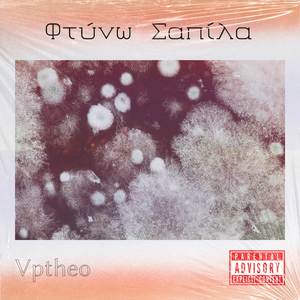
Φτύνω Σαπίλα

Απαλά Φύλλα
Mond Naturgeräusche, Μελωδίες φεγγαριού

Φύλλα Ξερά
Νεκτάριος Κλωστράκης, Γιάννης Κατάκης

Τρία Φύλλα
Σταμέλος Πέτρος

Ακίνητα Φύλλα
Μητέρα με συνειδητότητα - Σχολή Γιόγκα

Τρία Φύλλα
Πέτρος Σταμέλος

Φύλλα Φθινοπωρινά
Πέτρος Τζαμτζής

Φύλλα Φθινοπωρινά
Γιώργος Σπανός

Χορεύοντας Φύλλα
Οι πιο όμορφοι ήχοι της φύσης, Βαθύς ύπνος

Θροΐσματα Φύλλων
Master Daiko - Ελληνικά, LL Kids - Ελληνικά

Ψίθυροι στο Φύλλωμα
Μητέρα με συνειδητότητα - Σχολή Γιόγκα

Φύλλα φθινοπωρινά
The Creative Music Box

Φύλλα φθινοπωρινά
The Creative Music Box

Φύλλα φθινοπωρινά (Ορχηστρικό)
The Creative Music Box

Φύλλα Του Χρόνου
Guyos The Greek

Φύλλα Φθινοπώρου
Kyriakos Gabriel Varnava
Φτύνω Σαπίλα
Vptheo

Φύλλα που Θροΐζουν
Μουσική Διαστήματος για ύπνο

Φτύνω Σαπίλα
Vptheo

Παναγιούλα μου
Θανάσης Ρούπας, Φυλλιώ Πυργάκη

Ξύπνα μανούλαμ το πρωί
Θανάσης Ρούπας, Φυλλιώ Πυργάκη

Εψές αντάμα ήμαστε
Θανάσης Ρούπας, Φυλλιώ Πυργάκη

Σόλο κλαρίνο
Θανάσης Ρούπας, Φυλλιώ Πυργάκη

Γύραν τα ελατόκλαρα
Θανάσης Ρούπας, Φυλλιώ Πυργάκη

Στα Ρίτσα βγαίνει ένα νερό
Θανάσης Ρούπας, Φυλλιώ Πυργάκη

Λιβανατεϊκο
Θανάσης Ρούπας, Φυλλιώ Πυργάκη

Στη Ρούμελη και στο Μωριά
Θανάσης Ρούπας, Φυλλιώ Πυργάκη

Τι έχεις χάρε και χτυπάς
Θανάσης Ρούπας, Φυλλιώ Πυργάκη

Θοδωρίτικο
Θανάσης Ρούπας, Φυλλιώ Πυργάκη

Βασίλω κυρά Βασιλική
Θανάσης Ρούπας, Φυλλιώ Πυργάκη

Ιτιά
Θανάσης Ρούπας, Φυλλιώ Πυργάκη